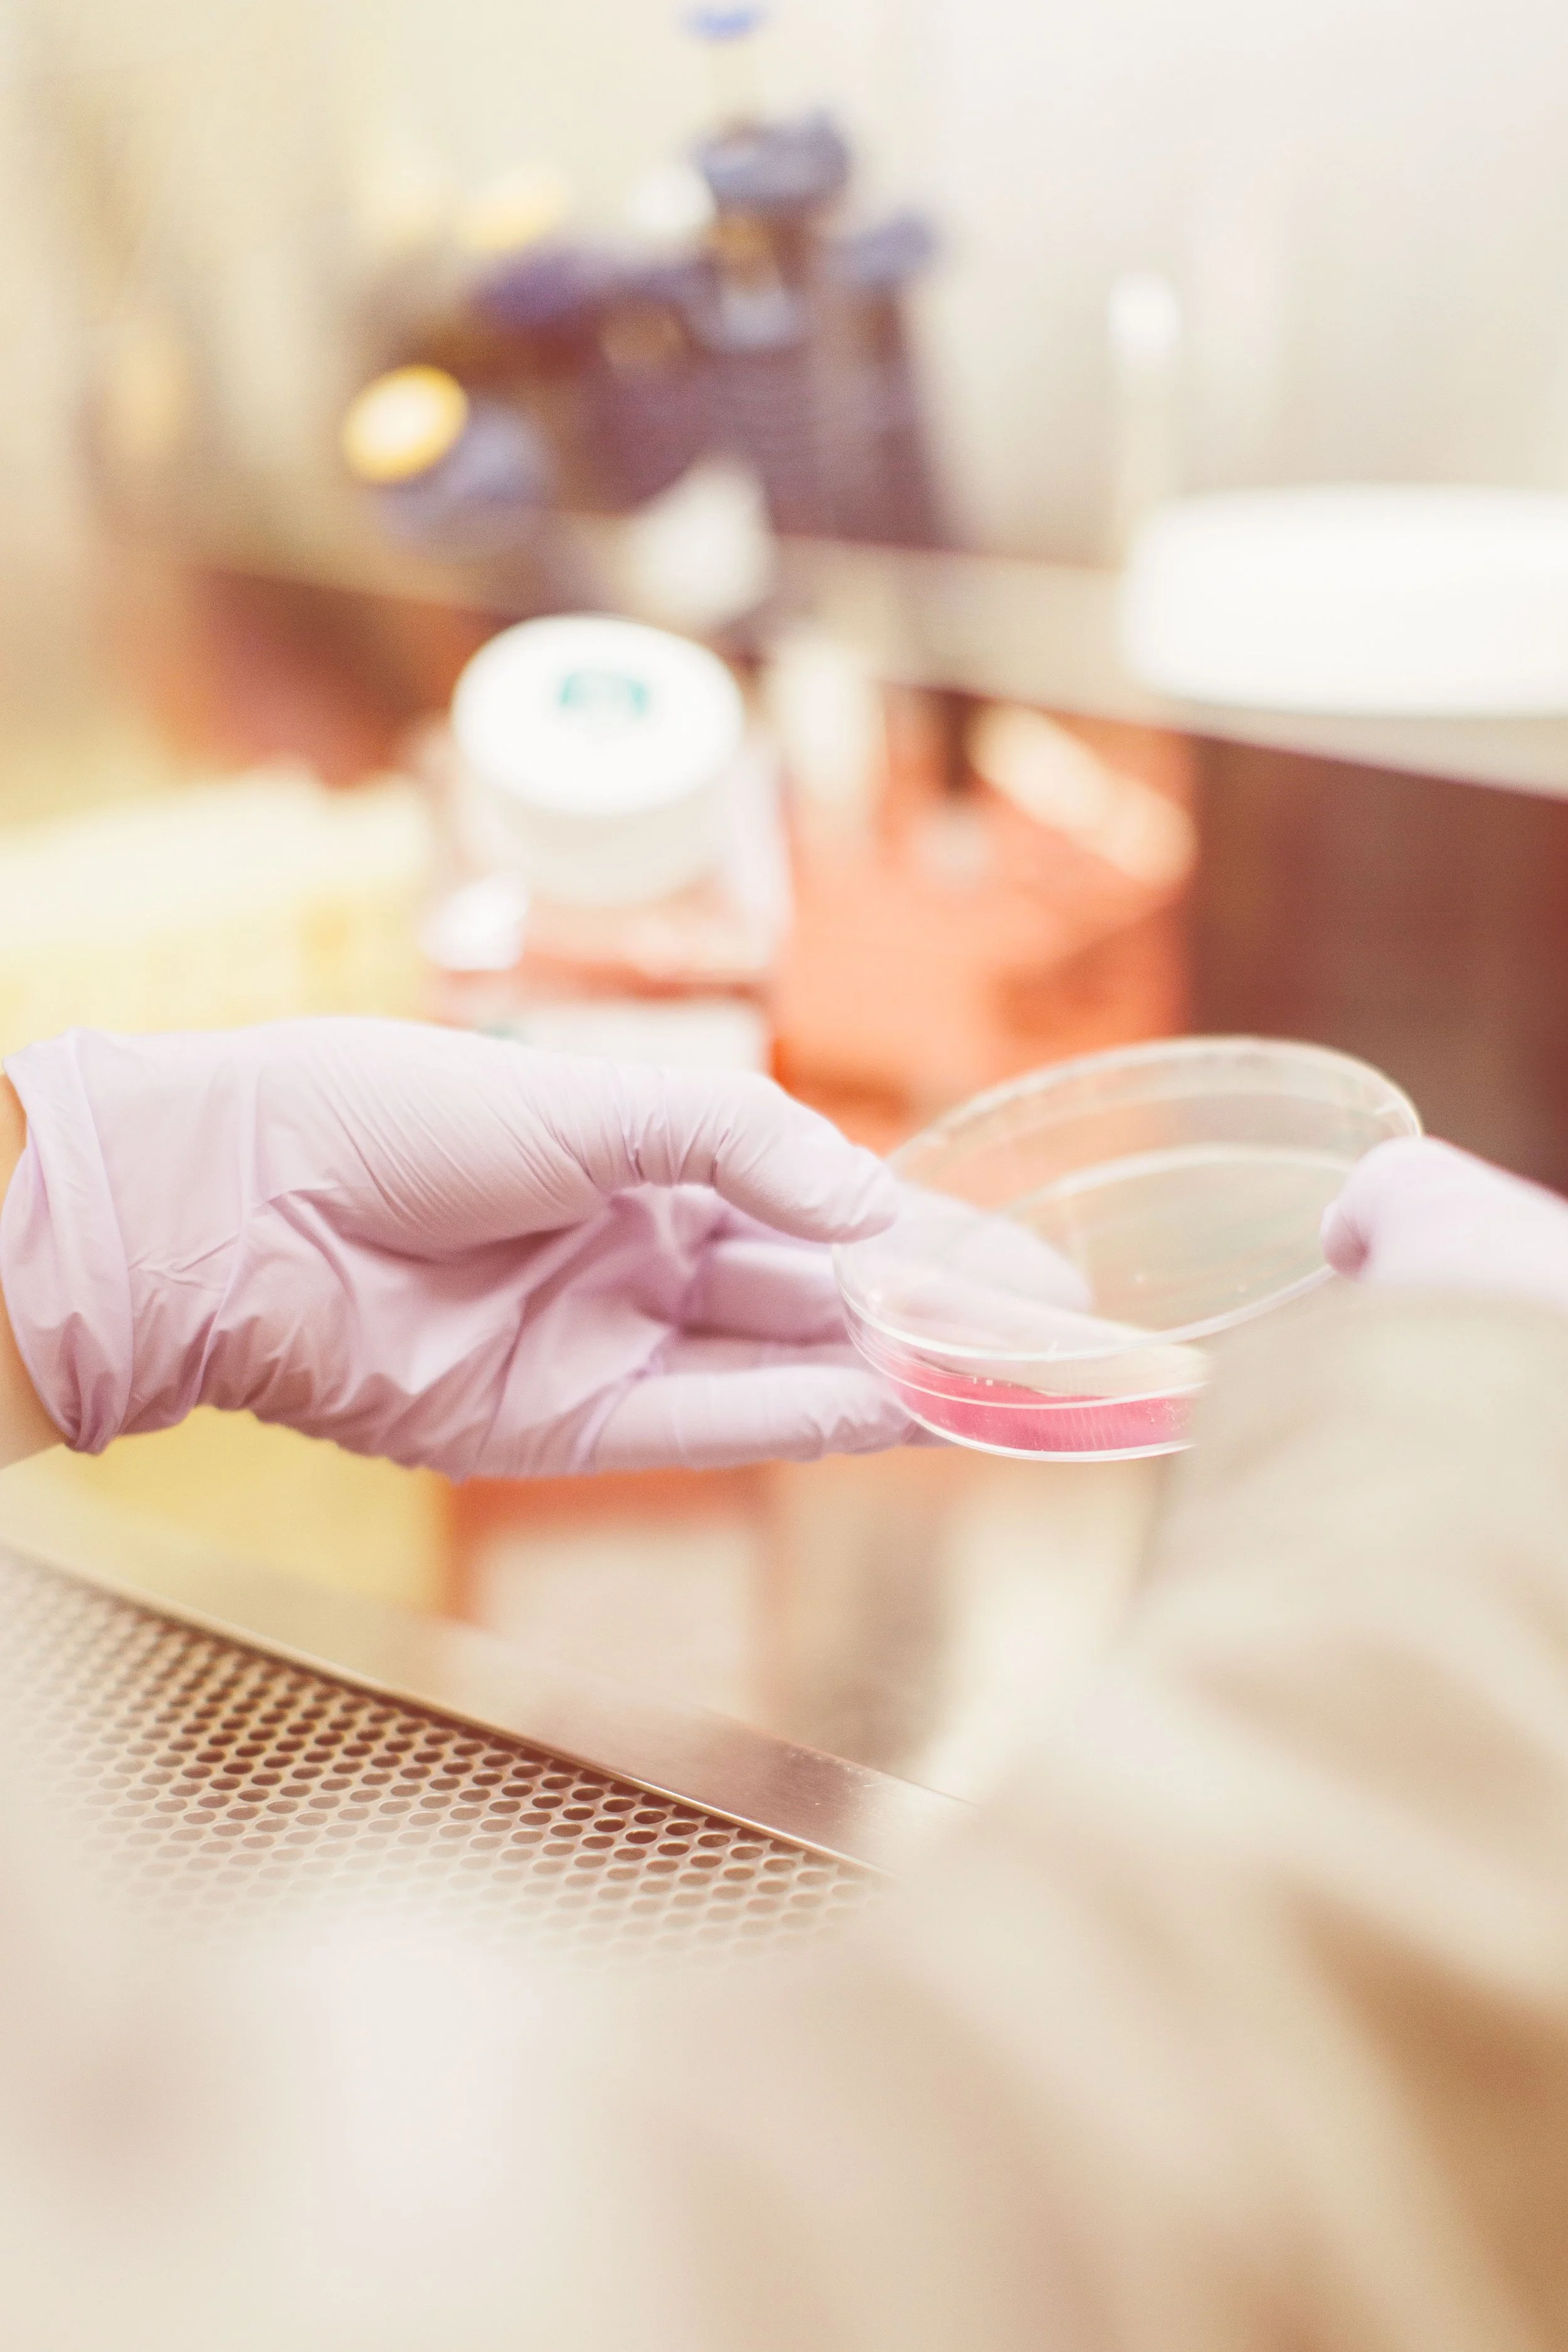

273. What Makes Life Worth Living Can Never Be Proven
We have somewhat of an evidential “problem” in our culture, which is somewhat interesting if you think about it, because it’s a relatively new phenomenon.
In other words, as we grew and evolved as a society, there wasn’t evidence of much of anything. We can imagine how this would go quite south, particularly when all we had on each other from a judicial standpoint and a medical standpoint was a hunch or word of mouth. But it’s interesting how evidence-based science is a relatively new phenomenon.
Even evidential information from a scientific perspective, while “accurate” has evolved into something non-accurate. We know of many situations where a particular solution to a problem was something which actually made us feel worse, unintentionally. Whether that was a pill or even a cognitive behavioral technique. Most famously, many very “normal” experiences and characteristics were considered to be mental illness up until a couple of decades ago.
It’s clear that on many occasions, evidence-based science and information is a good thing. But can it ever be not?
Well, in the instance that evidence-based information is unintentionally (or intentionally) skewed, this would be a serious detriment to the collective. Accidents happen and information can be either misinterpreted, or the energetic basis of it can change quickly over time. There’s lots of circumstances where we think we know something, but the solution or “answer” only comes in time. We can be so accustomed to only going to evidence-based information to treat and heal ourselves, yet we as people are so incredibly different from each other, we often tend to neglect either a spiritual root cause, or other differentiating factors about us. Over-reliance on this information can of course be a detriment.
One of the more interesting phenomenons is the collective’s general over-reliance on evidence-based information. I find it quite ironic because as someone who does energetic or channeling work, I’m often times lumped into pseudoscience. In other words, I am not “evidence-based”. Many people in these fields wish that the collective was more interested in facts, more interested in evidence. Yet if we think about it, for the most part our entire society acts on evidence. At least in comparison to before. The majority of our own decisions are based on “fact” in some way shape or form, or as we continue on our journey, we bump up to other people who are using facts, which we need to work with or work within. Facts generally rule our society.
I’ve heard people on TikTok say that the collective is more interested in “spiritual” practices, including pseudoscience when the world lacks information and answers. It’s their perspective that because facts and figures are failing them, they need to look into alternative options. But this isn’t a good thing. Adversely, my perspective is that we are never, ever satisfied as human beings with facts and figures, and we are simply existing in a point and place in time where we are so stretched, stressed and our environmental triggers are so exacerbated, that this is becoming increasingly obvious. Beyond the fact that facts and figures do fail.
The frustration that I have is that consciousness and intelligence/fact is always running parallel to fact. They never will be the same thing, and they never should be the same thing. They are governing bodies of our lives which need to have checks and balances. We must use consciousness interjection when/if our evidence fails us. If we learn more into consciousness, we can lean into prediction, observation, proactive intelligence, rather than just patterning and deduction. To me, consciousness and intuitive ability is the only reason that facts flourish. Because we can integrate into our own intuitive processes.
One could argue that we would either live in a flourishing society based upon facts, or a constricting society based upon facts. I think that either or is arguably correct. But either way, we’re ignoring the elephant in the room.
Matrix information and consciousness information runs parallel and overlaps. It always has been, and it always will. The frustration with facts and figures either sheds light onto two things. Facts and figures are not good enough, or the collective isn’t satisfied with them for one or more reasons. So what could these reasons be? One could potentially be that we are human beings and our operation is beyond facts and figures, so if we’re conditioned enough to believe that anything and everything we need is a calculated equation of happiness, we are and will be doomed to fail. Secondly, our spiritual integration is failing, and we’re projecting onto these facts and figures. But in my opinion, it’s the ping pong game that we play over and over again between matrix and consciousness. What’s winning? What needs work? On an individual but also a collective level.
The conversation really ends with the fact that our existence and our totality is so beyond a matrixed reality. We do not start and end at what can be quantified and deduced. We can use this information to live a more streamlined life, but there is no inherent value for our existence. The value that we have is our soul, our spirit, our thoughts, feelings and emotions. What we provide to ourselves, and what we provide to the collective. When we start treating facts and figures for what they are, which is tools to guide our life, we can have a healthier relationship and balance with both sides.